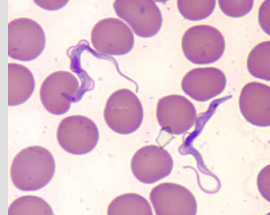
Trypomastigote
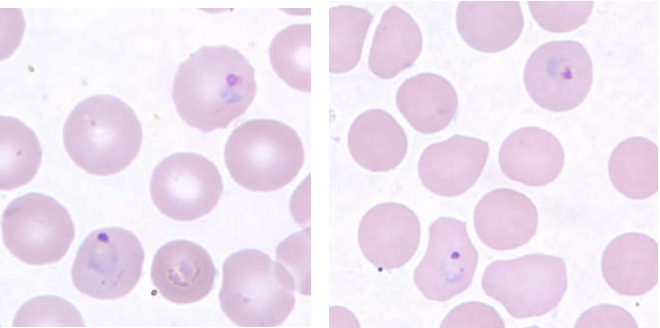
Trophozoite
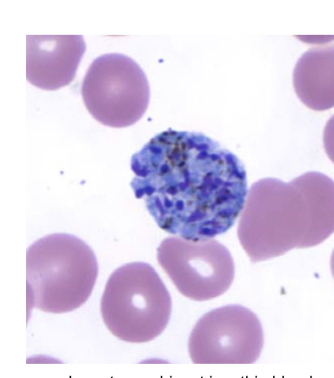
Schizont
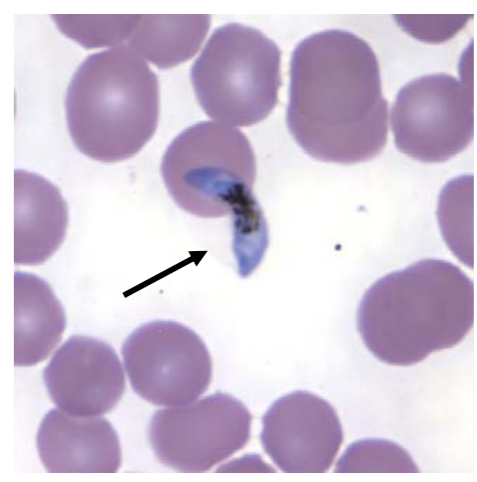
Gametocyte

Parasite Lab rev.1
0.0(0)
Studied by 2 peopleCard Sorting
1/35
Earn XP
Description and Tags
Last updated 4:00 PM on 3/6/23
Name | Mastery | Learn | Test | Matching | Spaced | Call with Kai |
|---|
No analytics yet
Send a link to your students to track their progress
36 Terms
1
New cards
SARCODINA
*Entamoeba histolytica, E.coli, Iodamoeba butschlii*
2
New cards
Phylum Retortomonada
*Chilomastix mesnili, Giardia intestinalis*
3
New cards
Phylum Parabasalia
*Trichomonas vaginalis*
4
New cards
Phylum Euglenozoa
*Trypamosoma brucei, T.cuzi, T. lewisi*
*Leishmania*
Vectors- *Glossina, Phlebotomus, Rhodnius*
*Leishmania*
Vectors- *Glossina, Phlebotomus, Rhodnius*
5
New cards
Phylum Dinoflagellata
*Noctiluca, Ceratium*
6
New cards
Phylum Apicomplexa
*Gregarina spp. Sarcocystis, Haemogregarina, Plasmodium vivax, P.falciparum*
7
New cards
Phylum Ciliophora
*Balantidium coli*
8
New cards
Phylum Myxozoa
*Myxobolus*

9
New cards
*Entamoeba histolytica*
Trophozoite

10
New cards
*Entamoeba histolytica*
Cyst

11
New cards
*E.coli*
Trophozoite

12
New cards
*E.coli*
Cyst

13
New cards
*Iodamoeba butschlii*
Cyst

14
New cards
*Chilomastix mesnili*
Trophozoite

15
New cards
*Giardia Intestinalis*
Trophozoite

16
New cards
*Giardia Intestinalis*
Cyst

17
New cards
*Trichomonas vaginalis*
Trophozoite

18
New cards
*Trypanosoma brucei*
Trypomastigote
19
New cards
*T.cruzi*
Trypomastigote

20
New cards
*T.lewisi*
Trypomastigote

21
New cards
*Leishmania*
Promastigote

22
New cards
*Leishmania*
Amastigote

23
New cards
*Glossina*
Tsetse fly- primary vector of Trypanosomes- T.*gambiense* and *T.rhodesiense*

24
New cards
*Phlebotomus*
*Leishmania* vector

25
New cards
*Rhodnius*
Trypanosome vectors-Chaga’s disease- African Kissing Bug-*T. cruzi*

26
New cards
*Noctiluca*
Trophozoite

27
New cards
*Ceratium*
Trophozoite

28
New cards
*Balantidium coli*
Trophozoite

29
New cards
*Balantidium coli*
Cyst

30
New cards
*Gregarina spp.*
Trophozoite

31
New cards
*Sarcocystis*
Zoitocyst

32
New cards
*Haemogregarina*
Gamont

33
New cards
*Plasmodium vivax*
Trophozoite
34
New cards
*Plasmodium vivax*
Schizont
35
New cards
*P.falciparum*
Trophozoite

36
New cards
*P.falciparum*
Gametocyte